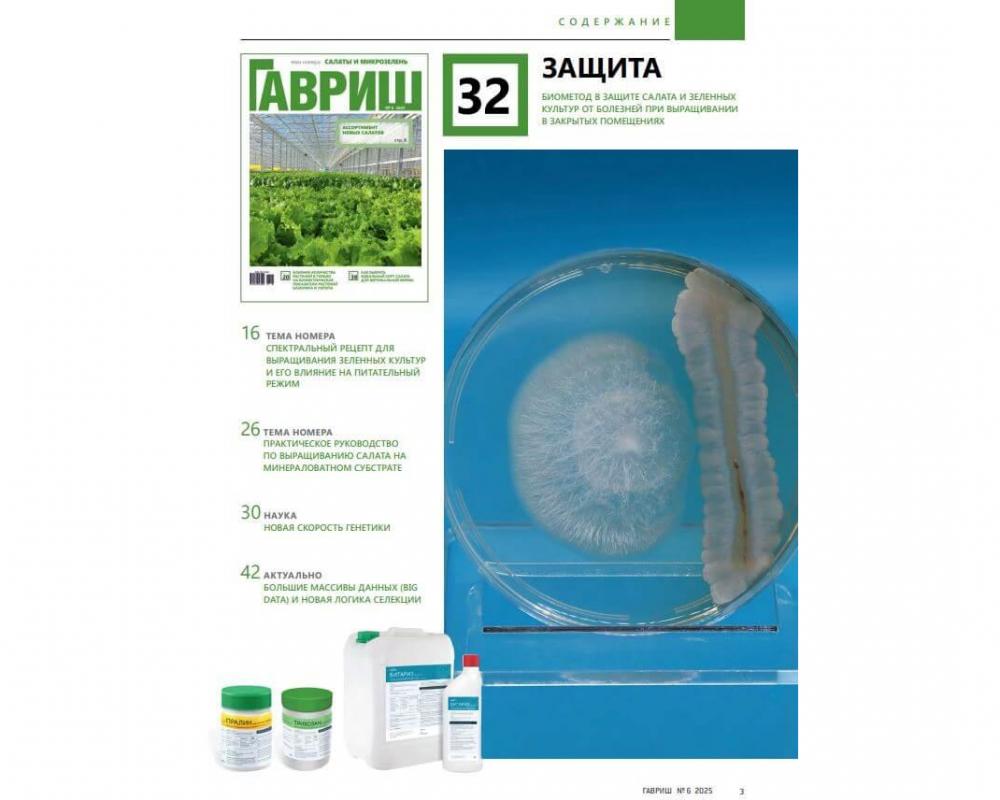
Эл. журнал "Гавриш" №6/2025

Эл. журнал "Гавриш" №6/2025
Купить онлайн Эл. журнал "Гавриш" №6/2025. Каталог Gavrish.shop предлагает журналы и профильные издания «Гавриш» для увлеченных опытных садоводов, для профессионалов защищённого грунта, для фермеров, для ландшафтных дизайнеров, питомников растений, а также специальную литературу для отдельных специалистов овощеводства и семеноводства.
Описание и характеристики Эл. журнал "Гавриш" №6/2025
Основан в 1995 г.
Выходит 6 раз в год
объем 80 страниц формат А4 полноцветная печать
Свидетельство о регистрации ПИ ФС77-73602 от 31.08.2018
Журнал “Гавриш” это — профессиональная информация для специалистов защищенного грунта.
Освещение событий и новейших разработок в свете современных мировых тенденций в секторе тепличного хозяйства, доступный стиль изложения, разнообразие тем и рубрик, независимость и компетентность экспертных оценок, интерактивность. Одна из основных задач журнала — ознакомление специалистов защищенного грунта с новыми сортами и гибридами, сортовыми технологиями, путями их освоения и эффективного использования.
Журнал регулярно информирует об особенностях новых технологий защищенного грунта, освещает вопросы аграрного законодательства, публикует статьи о достижениях и секретах мастерства профессионалов своего дела, рассказывает об этапах развития передовых тепличных хозяйств, размещает информационные и рекламные материалы, а так же статьи о тематических семинарах и дополнительном образовании в области защищенного грунта.
Подписчиками, читателями и авторами журнала «Гавриш» являются специалисты тепличных комбинатов России и СНГ, фирм-производителей семян, оборудования, пестицидов, удобрений, сотрудники научно-исследовательских учреждений и сельскохозяйственных вузов.
Учредитель и издатель журнала: ООО "Научно-исследовательский институт селекции овощных культур"
Соучредители: Министерство сельского хозяйства Российской Федерации
Главный редактор: Гавриш Сергей Федорович, доктор с.-х. наук, профессор, директор НИИ овощеводства защищенного грунта
Редакционный совет: Гиш Руслан Айдамирович, доктор с.-х. наук, профессор, зав. кафедрой овощеводства Кубанского ГАУ, научный редактор журнала; Кирий Петр Иванович, кандидат с.-х. наук, главный агроном ПАО «Комбинат «Тепличный», г. Киев (Украина); Король Валентин Григорьевич, доктор с.-х.наук Ситников Алексей Владимирович, канд.с.-х.наук, профессор ФГБОУ ВПО ГСХА, г. Кострома, член комитета Государственной Думы по аграрным вопросам Истомина Екатерина Александровна, кбн., научный сотрудник ИОГен им. Н.И. Вавилова РАН
• Журнал распространяется по подписке, на тематических семинарах компании «Гавриш»,
Ассоциации «Теплицы России», российских и международных отраслевых выставках.
Вы можете задать актуальный для вас вопрос, мы постараемся ответить на него на страницах журнала или индивидуально, привлекая специалистов НИИСОК и других компетентных учреждений.
Ваши письма с вопросами — лучшая оценка нашего труда.
Ваша поддержка — импульс к дальнейшей работе.
Приобрести журналы и другую печатную продукцию «Гавриш» вы можете с оплатой онлайн, с удобной доставкой почтой и транспортными компаниями по России и курьером по Москве и Московской области.
Заказ можно оплачивать также по счёту банковским переводом, а полный комплект документов, по вашему усмотрению вы сможете найти в личном кабинете «Гавриш Шоп». Издания «Гавриш» – это реальные отзывы фермеров на семена и урожайность, это технология выращивания и другой бесценный опыт из первых рук!